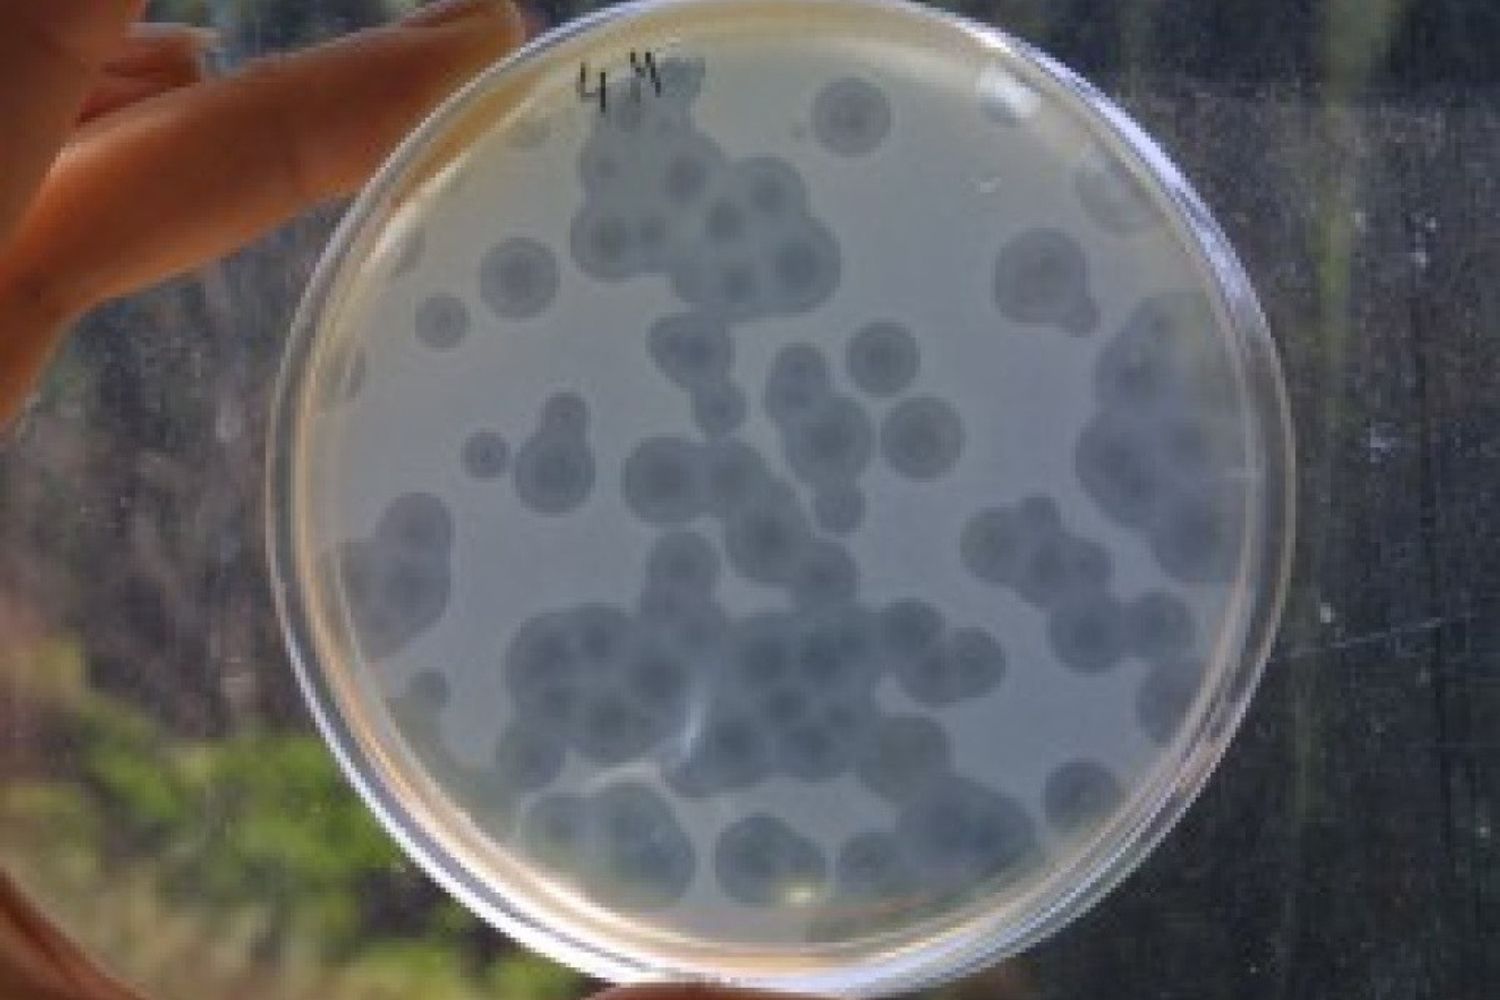
&nbsp;batteri

AGI - E' stata trovata in un rubinetto dell'ospedale della Donna e del Bambino di Borgo Trento (Verona) la causa del decesso di quattro neonati e della malattia di altri 96. Lì, probabilmente a causa della scarsa igiene, si era infatti annidato il Citrobacter.
E' quanto emerge dalla relazione della commissione d'inchiesta nominata dalla Regione Veneto.
La relazione, come confermato dal governatore Luca Zaia, verrà ora consegnata alla Procura della Repubblica per l'apertura di un'inchiesta.
I primi controlli da parte dei vertici dell'Azienda ospedaliero-universitaria di Verona erano stati avviati lo scorso gennaio poi erano stati interrotti a causa dell'emergenza Coronavirus. Il reparto di Ostetricia - Punto nascite, Terapia intensiva neonatale e Terapia intensiva pediatrica, dopo la completa sanificazione, è stato riaperto oggi.